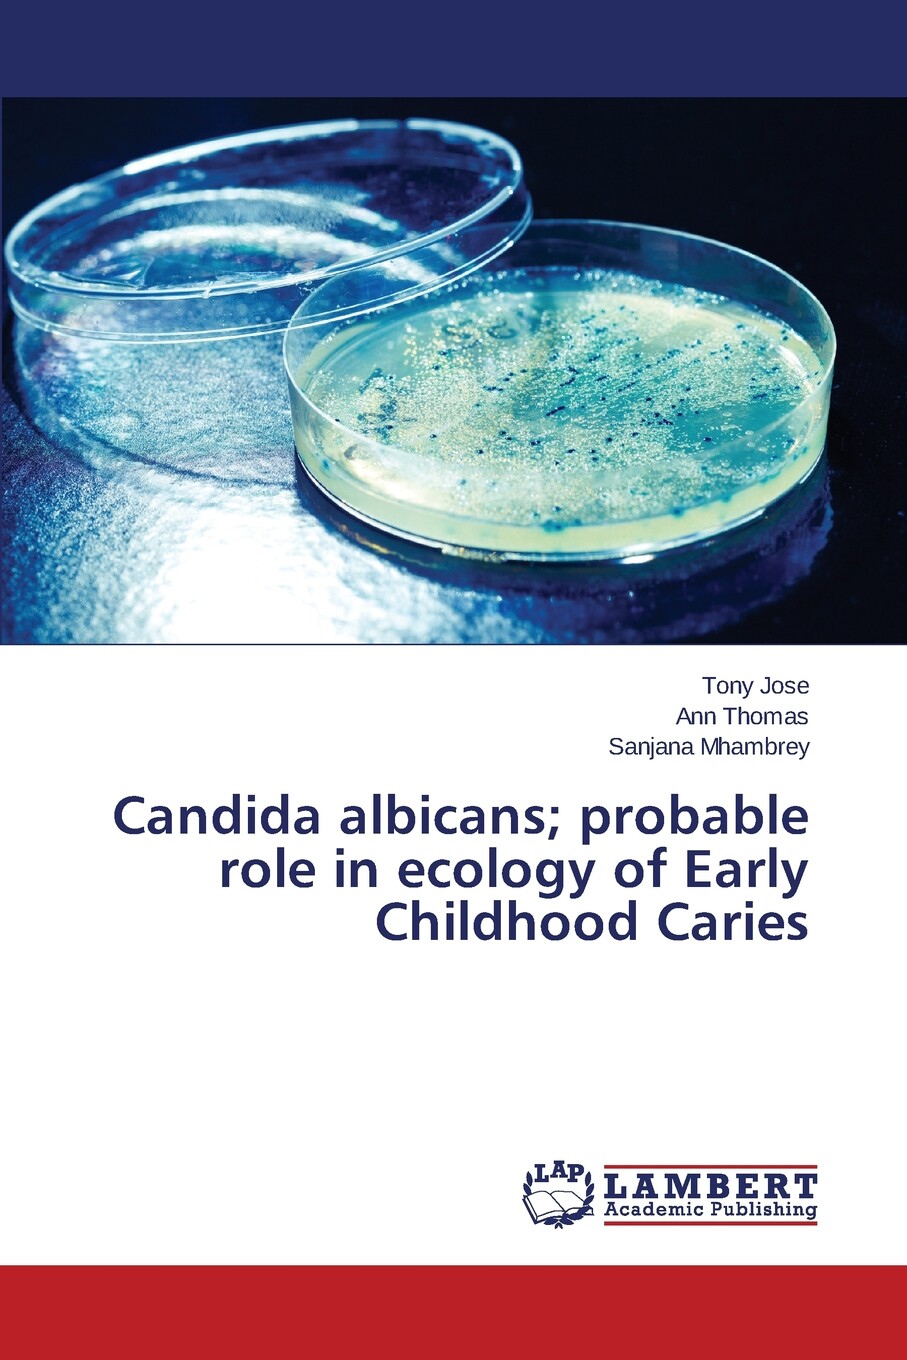
【预售 按需印刷】candida albicans; probable role in ecology of

candidaalbicans

【4周达】candida albicans
图片尺寸800x800
【4周达】candida albicans: the non-drug approach to the
图片尺寸800x800
预订 candida albicans: natural remedies for yeast infection
图片尺寸341x522
预订 candida albicans: a beginners 5-step to managing the
图片尺寸267x400
【4周达】candida albicans: cellular and molecular biology
图片尺寸800x800
【4周达】candida albicans: methods and protocols
图片尺寸800x800
candida albicans
图片尺寸1200x600
candida albicans phil 3192 lores
图片尺寸792x528
candida albicans - yeast diaper rash
图片尺寸640x401
medicinal cannabis available on prescription
图片尺寸1920x1279
【4周达】candida albicans and complete dentures - mystery
图片尺寸800x800
培养皿里的白色念珠菌(candida albicans).
图片尺寸550x366
【4周达】candida albicans; probable role in ecology of early
图片尺寸800x800
【预售 按需印刷】candida albicans; probable role in ecology of
图片尺寸907x1360
isolated candida albicans oligopeptide transporter gene
图片尺寸2714x3993
candida albicans
图片尺寸450x275
按需印刷】efficacy of denture cleansers against candida albicans
图片尺寸907x1360![按需印刷postgenomic studies of candida albicans[9783836492706]](https://i.ecywang.com/upload/0/t14.baidu.com/it/u=3166839165,436563951&fm=224&app=112&f=JPEG?w=500&h=500)
按需印刷postgenomic studies of candida albicans[9783836492706]
图片尺寸800x800
大麻收藏3d模型
图片尺寸1480x1480
3d illustration of fungi candida albicans which cause
图片尺寸450x320

















![按需印刷postgenomic studies of candida albicans[9783836492706]](https://i.ecywang.com/upload/0/t14.baidu.com/it/u=3166839165,436563951&fm=224&app=112&f=JPEG?w=500&h=500)

![按需印刷postgenomic studies of candida albicans[9783836492706]](https://img.alicdn.com/bao/uploaded/i4/1899623276/O1CN01JlFF261a4SHPMwllr_!!0-item_pic.jpg)

